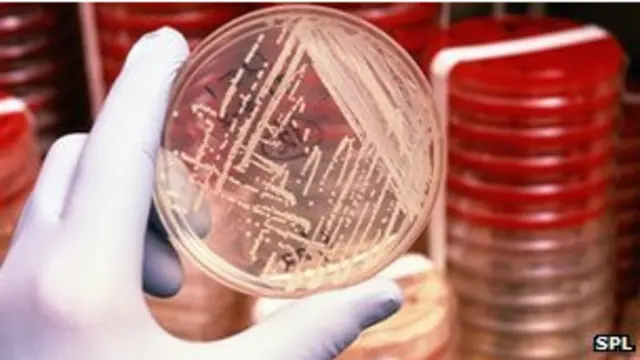
Мікроби

Вчені створили найповнішу карту людських мікробів

- Author, Смітха Мундасад
- Role, BBC News
"Коли я встаю зі стільця, то насправді серед цієї маси клітин, які встають зі мною, у десятки разів більше клітин бактерій, аніж клітин людського тіла", - каже доктор Брюс Біррен.
Він один із сотень американських науковців, залучених до наймасштабнішого світового проекту зі створення карти мікробів, які живуть усередині наших тіл і на них.
Проект <link type="page"><caption> "Мікробіом людини"</caption><url href="http://commonfund.nih.gov/hmp/" platform="highweb"/></link> описує генетичні дані багатьох бактерій, вірусів та інших організмів, які живуть у близькому контакті з нами.
Мікробіом – це набір мікробів з усіма їхніми особливостями та взаємними зв’язками, які населяють людське тіло.
І це переважно не ті мікроорганізми, яких потрібно позбуватися. Навпаки, вони складають фундаментальну частину того, що робить нас людьми, кажуть дослідники.
Однак ще донедавна про трильйони мікробів, які населяють наші тіла, було відомо небагато.
Корисні мікроорганізми
Протягом століть ми могли досліджувати лише тих мікробів, які можуть вижити в лабораторних умовах, і вивчати їх в ізоляції – лише кожного мікроба окремо від інших.
Однак з появою дедалі досконаліших технік для вивчення послідовностей ДНК учасники проекту "Мікробіом людини" змогли виявити невідомі раніше мікроби і простежити за їхньою колективною поведінкою.
Багато результатів цього проекту, запущеного п’ять років тому Національним інститутом здоров'я, було опубліковано в журналах Nature, Genome Biology та PLoS.
Вчені взяли зразки мікробів з різних частин тіл понад 200 здорових чоловіків і жінок. Дослідникам вдалося виявити понад 10 тисяч різних типів організмів, які входять до мікробіому здорової людини.
Виявилося, що більшість із цих мікробів не завдають нам ніякої шкоди. Насправді, дедалі більше фактів свідчать про те, що ці мікроорганізми у різний спосіб допомагають людям.
Декотрі з них дозволяють нам отримувати енергію з їжі, а інші – поглинати корисні речовини, такі як вітаміни.
У кожного свої мікроби?
Ми дізнаємося, що вони впливають скоріше на формування нашої імунної системи, аніж на загрози їй, каже професор Барбара Мес з Інституту Крейда Вентера, яка також бере участь у проекті.
Одне з ключових питань, на яке дослідники шукали відповідь, таке: чи існує основний набір мікробів, присутній в кожному людському тілі?
Насправді вчені виявили різноманітних мікробів у різних людей і унікальні колонії мікроорганізмів, які живуть у різних ділянках тіл.
Однак по-справжньому деяких дослідників здивувало те, що в певних частинах тіл багато різних мікробів роблять одну і ту ж роботу.
"На моєму язиці можуть бути інші мікроорганізми, ніж на вашому, але колективно вони задіюють одні й ті самі гени – так, що вони можуть виконувати одні й ті самі функції, наприклад, розкладати цукор", - каже доктор Біррен.
Такі відкриття можуть привести до переоцінки одномікробної моделі захворювання, яка покладає провину на виникнення конкретної хвороби на якийсь один мікроорганізм.
"Каталог бактерій"
Можливо, при деяких недугах грає роль не певний тип мікроба, а те, що в діяльності групи мікроорганізмів щось пішло не так, пояснює доктор Гаттенговер.
Дослідники виявили, що в здорових добровольців було менше мікробів, яких традиційно вважають збудниками хвороби.
Наприклад, бактерію золотистий стафілокок, яка задіяна в інфекції МРЗС, знайшли в носах 30% добровольців.
Автор фото, SPL
"Зараз у нас є каталог із сотнею цих мікроорганізмів, які, перебуваючи в правильному середовищі, потенційно можуть зробити щось не так. Ми знаємо, де саме в здорових людей вони живуть і які організми їх оточують. Тому, можливо, ми можемо наблизитися до розуміння, що тримає їх під контролем і де розміщені їхні сховища", - каже доктор Куртіс Гуттенговер із Гарвардської школи громадського здоров'я.
Мікроби носять у собі багато власних генів. Ці гени можуть так само впливати на наше здоров'я і бути чинниками ризику, як і наші власні гени, каже доктор Гуттенговер.
За його словами, в далекій перспективі особливо цінною стане можливість наводити довідки в цій новій генетичній базі даних та досліджувати мікробіоми, які не входять до неї.
"Незвідана територія"
Доктор Літа Проктор, програмний директор проекту, каже, що зараз з'являється дедалі більше свідчень на користь того, що ми набуваємо свої мікробіоми на найраніших стадіях життя.
"Людина успадковує свій геном, але мікробіом у нас набутий – це означає, що він має дуже важливу, змінну, мутабельну властивість. Тому нам є над чим працювати в клінічних дослідженнях. Якщо ми навчимося змінювати мікробіом, то навчимося підтримувати здоровий мікробіом у здоровому стані або відновлювати баланс у випадку з нездоровим набором мікробів", - каже вона.
Але кому належать мікробіоми, які населяють наші тіла? І що це означає для розробки пробіотиків, які можуть змінювати їх? – запитує спеціаліст з етики, доктор Емі Маꥳр із Бейлорського медичного коледжу.
Розширюючи свої знання в цій сфері, ми повинні дати відповіді на ці запитання, каже вона.
Однак поки що ми лише на півдорозі. Нам потрібно дізнатися значно більше про те, як мікробіоми комунікують з клітинами людського тіла, каже професор Девід Релман зі Стенфордського університету.
"Ця територія досі незвідана. І хоча вона лежить на рідній землі, ми досі знаходимо на ній нові форми життя", - каже він.








